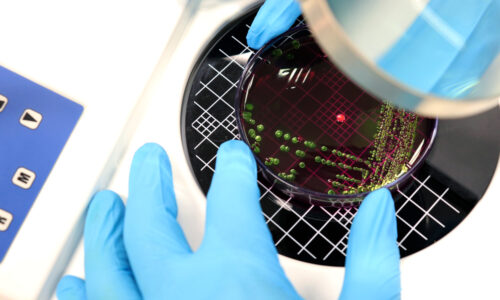
Bacterial count in next-generation probiotics: AFU technology

What are NGPs?
The International Scientific Association for Prebiotics and Probiotics defines probiotics as “Live microorganisms that, when administered in adequate amounts, confer a health benefit on the host.”1
Traditionally probiotic products have comprised a narrow spectrum of micro-organisms, mostly containing strains from the bifidobacterium or lactobacillus genera isolated from fermented foods.
Recently however, scientists have turned their attention to new species that could confer benefit to the host, with the novel organisms being referred to as “next generation probiotics” or NGPs. Species within this category include Eubacterium hallii, Faecalibacterium prausnitzii, Roseburia spp., Akkermansia muciniphila, and Bacteroides fragilis or they can be innovative engineered strains designed to perform a specific function. These strains are often sourced from the gut and are anaerobic by nature.
How do NGPs differ from existing probiotics?
Contrasted with traditional probiotics, NGP species have been identified for their specific health benefits and function. These functions include short-chain fatty acid production, intestinal barrier regulation and immune system modulation.
Some NGP spp. have been associated with disease states. For instance, in 2008 the Sokol lab documented a depletion of Faecalibacterium prausnitzii in the gut microbiome of Crohn’s disease patients, with its lower abundance being linked to a higher risk of clinical flare.2
The NGP Landscape
The newness of the NGP market makes it a very exciting area of microbiome research, forecasted to more than double in size from 231 million USD in 2025 to 486 million USD by 2032.3 Companies are utilizing the unique properties of NGPs to provide consumers and patients with novel health benefits.
Pendulum Therapeutics
Based in San Francisco and founded in 2012, Pendulum Therapeutics has raised $111M to date.4 Pendulum therapeutics offers a variety of OTC probiotics, all containing A. muciniphila as well as other NGP strains. Naturally occurring in the gut, A. muciniphila has been associated with improved metabolic health, including a reduction in obesity risk and an increase in heart health.5
In March 2024, they launched their GLP-1 Probiotic, consisting of the 2 NGP strains A. muciniphila and Clostridium butyricum.6 Pendulum reference various preclinical studies to support their claim that their GLP-1 Probiotic can upregulate GLP-1 secretion in the host. One such study found that a metabolite secreted by A. muciniphila increased GLP-1 secretion in mice. In unpublished company data, Pendulum also reports a dose-dependent increase of GLP-1 by Clostridium butyricum in a cell-based assay. The company is currently testing their GLP-1 probiotic in a clinical trial with completion expected in 2025.7 The company also has active trials examining the impact of their NGPs on bipolar disorder, and bone health.
The Akkermansia Company
Also leveraging the health benefits of A. muciniphila is the Akkermansia Company in Belgium. Founded in 2004, the company was founded on the discovery of A municinphila by Willem M. de Vos’ laboratory of Wageningen University and the Patrice Cani’s research from UCLouvain. To date it has raised $21.9M in funding.8 Notably, The Akkermansia Company utilise a proprietary pasteurised form of A. muciniphila, Akkermansia MucT. Their product “Healthy Weight” has been available in Europe since 2021 and launched into the US in June 2024.9
In 2019, a randomised double-blind study conducted by The Akkermansia Company, the Microbes4U® study, found pasteurized A. muciniphila improved insulin sensitivity, reduced insulinemia and reduced plasma total cholesterol compared to the placebo in human subjects – interestingly, only the pasteurised form led to reduced cholesterol versus the live form.10 Bolstering these findings, a paper in Nature identified that pasteurised Akkermansia better strengthened intestinal integrity and lipid metabolism than the live form in a tissue model. 11
ClostraBio
A spin-out from the University of Chicago, ClostraBio are developing an NGP for targeted delivery of butyrate to promote gut health and intestinal barrier integrity. Butyrate is critical to gut homeostasis, as it serves as the primary carbon source for colonocytes and promotes barrier integrity by upregulating tight junction proteins12 and increasing mucin production13. However, decreased butyrate levels have been observed in individuals afflicted with numerous chronic diseases12,14 as well as those consuming a Western diet15,16. ClostraBio’s CLB101 is an NGP that has been shown to produce high levels of butyrate from fermentation of prebiotics as well as from the lactate and acetate excreted by common gut commensals like Bifidobacteria17. Manufacture of CLB101 has been successfully scaled to commercial capacity with a planned product launch in 202518.
Florey Biosciences
Spun out from Cubillos-Ruiz’s research in the MIT and Wyss Institute lab of James Collins, Ph.D., Florey Biosciences are developing genetically engineered probiotics to improve human health. Their lead product FLR-101, consists of a food-grade yeast strain which produces an enzyme to degrade beta-lactam antibiotics – which represents approximately 50% of antibiotics used. Antibiotic consumption significantly disrupts the fragile balance of the gut microbiome, an inconvenient side-effect of a highly useful drug class. Florey aim to eliminate this side-effect by shielding the gut microbiome with the beta-lactam degrading effects of FLR-101. As the yeast is localised to the gut, the antibiotics can still act on infection elsewhere in the body.19 Currently, Florey are pursuing a medical food designation for their probiotic product.
In a 2022 proof of concept paper, the team demonstrated in vivo that an engineered strain of Lactococcus lactis could effectively degrade beta-lactam in the gut of mice, without impacting the serum levels of the antibiotic. The paper notes that the beta-lactamase gene does not confer antibiotic resistance to the host strain and is not susceptible to horizontal gene transfer.20
Looking to develop an NGP?
In addition to our world-leading LBP manufacturing solutions, Biose Industrie have fully anaerobically sealed industrial production lines for NGPs with over 600 different strains being manufactured for the different clients around the world!
If you are interested in manufacturing a NGP product, get in touch here.

Sources:
- https://isappscience.org/for-scientists/resources/probiotics/
- https://pubmed.ncbi.nlm.nih.gov/18936492/
- https://www.coherentmarketinsights.com/market-insight/next-generation-probiotics-market-5468#:~:text=Next%20Generation%20Probiotics%20Market%20is,technological%20robustness%2C%20and%20regulatory%20framework.
- https://tracxn.com/d/companies/pendulum/__luVW54RO5auUerhcc7Q13foJzCh3cnrhYFPDQPxijj4
- https://pmc.ncbi.nlm.nih.gov/articles/PMC8726741/
- https://www.prnewswire.com/news-releases/pendulum-therapeutics-introduces-glp-1-probiotic-302087492.html
- https://pendulumlife.com/pages/research-clinical-trials
- https://tracxn.com/d/companies/the-akkermansia-company/__4YBN0NiDL_m1dVG3gqB8tqCu-XPJDph8X-niTLucL6A/funding-and-investors
- https://www.nutraingredients-usa.com/Article/2025/03/06/the-akkermansia-co-on-weight-management-with-akkermansia-muciniphila/#:~:text=The%20Akkermansia%20Company%20launched%20into,decoded%20by%20the%20company’s%20founders.
- https://pubmed.ncbi.nlm.nih.gov/31263284/
- https://www.nature.com/articles/s41598-021-95738-5
- https://pubmed.ncbi.nlm.nih.gov/36502573/
- https://pubmed.ncbi.nlm.nih.gov/34819742/
- https://pubmed.ncbi.nlm.nih.gov/30643289/
- https://pubmed.ncbi.nlm.nih.gov/26742586/
- https://pubmed.ncbi.nlm.nih.gov/36177011/
- https://pubmed.ncbi.nlm.nih.gov/16672507/
- https://clostrabio.com/about.html
- https://www.fiercebiotech.com/research/florey-biosciences-spins-out-harvards-wyss-institute-cook-proven-probiotic-medical-foods
- https://pubmed.ncbi.nlm.nih.gov/35411114/